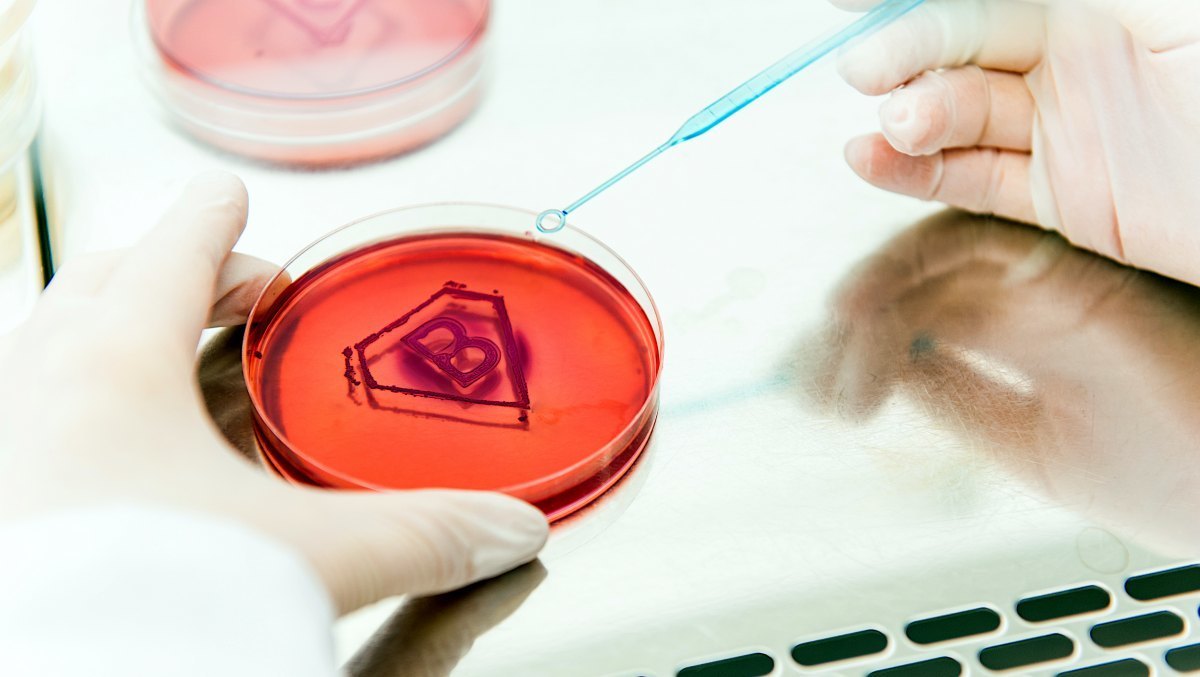
img_20250120134152_289dd991.jpg

“25년간 4000만명 사망할 것”…심상치 않은 경고
국내 항생제 내성 관리 예산은 지난해 기준 17억 6000만원
항생제 내성 문제가 전 세계적으로 심각한 공중보건 위협으로 부상하고 있는 가운데, 앞으로 25년간 '슈퍼박테리아'로 인해 전 세계에서 약 4000만명이 사망할 것으로 보인다는 예측이 나왔다.
기사의 이해를 돕기 위한 이미지. / borzywoj-shutterstock.com
기사의 이해를 돕기 위한 이미지. / borzywoj-shutterstock.com슈퍼박테리아는 여러 항생제에 내성을 가진 '다제내성균'을 의미한다. 항생제를 과도하게 사용하면 세균이 유전자 변이를 통해 내성을 갖게 된다. 이로 인해 다제내성균에 감염된 환자는 기존 항생제로 치료가 어려워진다.
지난 5일(현지시각) 샐리 데이비스 전 영국 정부 최고의학자문관은 영국 언론 매체 '더 가디언'을 통해 "항생제 비상사태가 커지고 있다"고 경고했다.
그는 "매년 약 백만명이 다제내성균으로 사망하고 있으며, 이 수치는 향후 25년 동안 증가할 것으로 보인다"며 "약 4000만명이 목숨을 잃을 것으로 예상된다. 특히 노인들이 큰 위험에 처해 있다"고 밝혔다.
데이비스 박사는 항생제 과다 사용이 문제의 원인이라고 지적했다. 그는 "가축에게 성장 촉진제 대신 항생제를 사용하면서 다제내성균이 진화하고 내성이 퍼지고 있다"며 "또한, 집약적 농업 지역이나 하수 처리 시설이 미비한 병원에서 다제내성균이 수로를 통해 유입될 가능성도 있다"고 주장했다.
전문가들은 다제내성균 문제를 해결하기 위해서는 새로운 항생제 개발이 필요하다고 조언한다. 그러나 항생제는 일 년에 한 번 주 1회 사용하는 데 그쳐 이익 창출이 어렵다. 반면, 매일 복용해야 하는 혈압약이나 항암제는 제약회사에 큰 이익을 가져다준다.
국내에서도 다제내성균 경고의 목소리가 커지고 있다.
더불어민주당 박희승 의원과 대한요로생식기감염학회는 국회에서 '항생제 다제내성균 요로감염의 효과적 통합 대응체계 구축 정책토론회'를 개최했다. 항생제 내성 감염증 사망자가 6년 새 17배 급증했으며, 요로감염과 같은 흔한 감염 질환에 항생제를 빈번하게 사용한 탓이다.
2021년 한국의 항생제 사용량은 19.5DID(인구 1000명당 1일 항생제 소비량)로 OECD 평균 15.9DID를 초과한다.
그러나 항생제 내성 관리 예산은 지난해 기준 17억 6000만원에 불과하다.
가톨릭대 의정부 성모병원 배상락 교수는 "국내 항생제 내성 관리 예산 증액과 임상 현장 의견을 반영한 대책 마련이 필요하다"고 말했다.